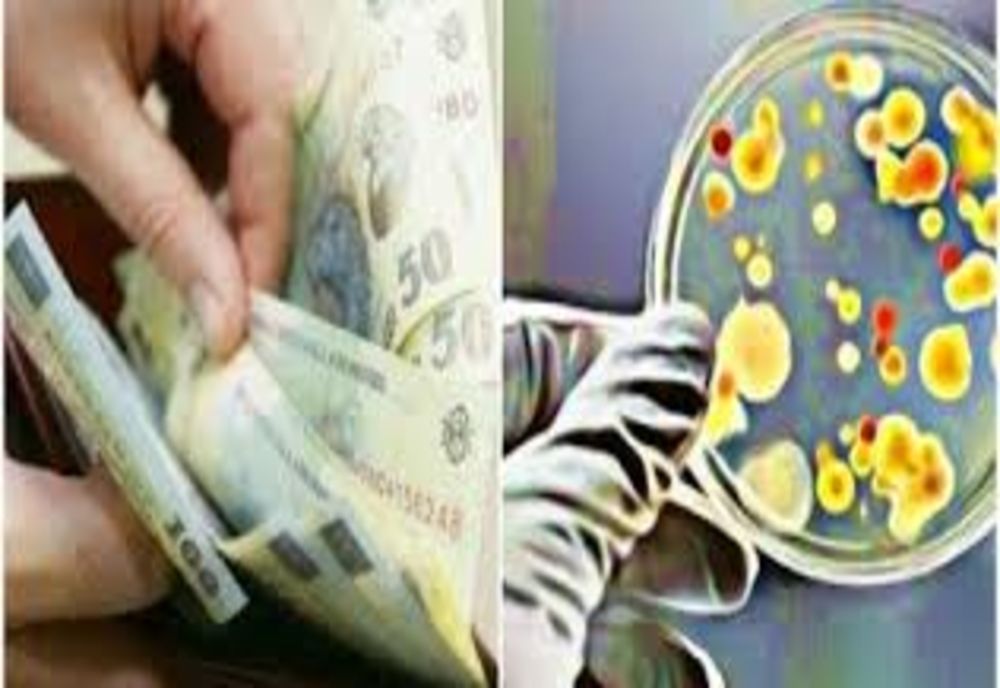
Direcţia de Finanţe Publice Municipale recomandă interacțiunea de la distanță în următoarea perioadă. BNR: Banii cash sunt cei mai periculoși când e vorba de răspândirea unei epidemii

Direcţia de Finanţe Publice Municipale recomandă interacțiunea de la distanță în următoarea perioadă. BNR: Banii cash sunt cei mai periculoși când e vorba de răspândirea unei epidemii
Direcţia de Finanţe Publice Municipale recomandă interacțiunea de la distanță în următoarea perioadă. BNR: Banii cash sunt cei mai periculoși când e vorba de răspândirea unei epidemii
"Banii cash sunt murdari la propriu, sunt cei mai periculoşi când vine vorba de răspândirea unei epidemii!"
În contextul răspândirii infecției cu coronavirus (COVID-19), Direcția de Finanțe Publice Municipale Sfântu Gheorghe recomandă interacțiunea de la distanță cu organul fiscal și reamintește contribuabililor că obligațiile fiscale se pot îndeplini utilizând metode de comunicare la distanță, astfel:
– pentru depunerea declarațiilor fiscale și comunicarea documentelor justificative, prin intermediul poștei electronice, pe adresa de e-mail [email protected], prin completarea și scanarea declarației de impunere, respectiv a cererii de comunicare electronică a actelor administrativ fiscale; în acest sens se pot accesa formularele tip ce urmează a fi completate la http://www.sfantugheorgheinfo.ro/index.php?page=30#fragment-515, ori prin fax la nr. 0267 311 303, ori prin poștă sau curierat la adresa Sfantu Gheorghe, str. Oltului nr. 2.
– pentru plata impozitelor și taxelor locale:
– orice informație legată de situația fiscală a persoanelor fizice sau juridice poate fi solicitată prin e-mail la adresa [email protected], ori telefonic la numerele de telefon:
0736 883 567 (Biroul Constatare, Impunere, Control Persoane Fizice)
0736 883 569 (Biroul Constatare, Impunere, Control Persoane Juridice)
0736 883 568 (Biroul Executări Silite)
"Banii cash sunt murdari la propriu, sunt cei mai periculoşi când vine vorba de răspândirea unei epidemii!"
Consilierul de strategie al guvernatorului Băncii Naționale a României, Adrian Vasilescu, avertizează că banii cash sunt o metodă de transmitere a virusului.
Acesta spune că singura „provizie” pe care și-a făcut-o el în această perioadă a fost să renunțe la folosirea banilor cash: „O singură provizie am făcut: de card. Pentru că nu mai umblu cu bani în buzunar. Banii sunt cei mai periculoși, când e vorba de răspândirea unei epidemii”.
România are un avantaj din acest punct de vedere, pentru că avem bani din plastic și aceștia pot fi spălați, așa cum au procedat și autoritățile din China
Citește și:
- 15:50 - Complot dejucat în Serbia: doi bărbați, suspectați că plănuiau asasinarea lui Vučić
- 13:52 - Bogdan Hossu spulberă noua lege a salarizării. ”Sporurile pentru condițiile de muncă au scăzut” -VIDEO
- 13:24 - Cristian Mungiu a câștigat un premiu important la Cannes, cu filmul Fjord
- 11:27 - Trei coliere de aur de peste 300 de grame şi vechi de 3000 de ani, descoperite în Prahova
Urmărește știrile Realitatea de Covasna și pe Google News














